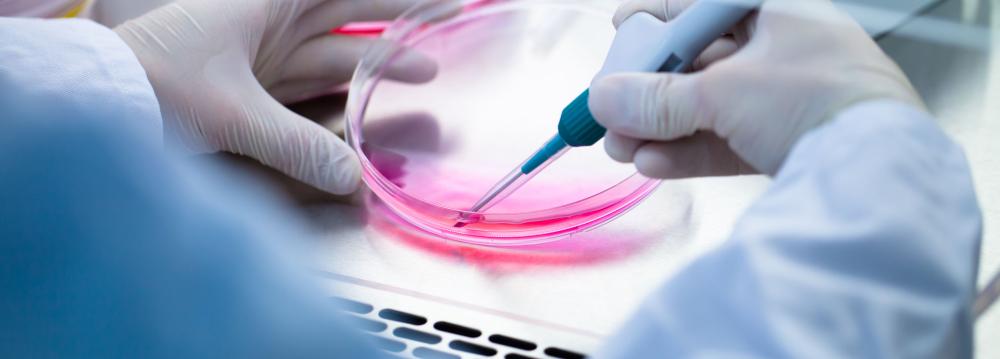

The biggest national project to treat patients with Cerebral Palsy (CP) through injection of stems cells from umbilical cord blood into the brain will be trialed in the country by the end of the current year in March, said Dr. Morteza Zarrabi, head of Royan Institute.
The plan will be implemented jointly by Royan Institute, Children’s Medical Center (affiliated to Tehran University of Medical Sciences), and Iranian Blood Transfusion Organization.
“In the first phase, it would provide treatment to 130 children with CP between the ages 5-13,” IRNA quoted him as saying, on the sidelines of the conference ‘Stem Cells and Their Potentials for Clinical Application,’ held at Kashan University of Medical Sciences Thursday.
In September 2016, the treatment was tried out in a few children with CP in some hospitals, and the results were satisfactory, he said.
Many questions must be answered before stem cell treatment becomes a success in the medical field such as: which of the various types of stem cells would be the best to use; what is the best way in which to use these cells and how will they affect the body; when does the treatment need to be given to achieve the best result; and should the cells be injected directly into the damaged area of the brain or into the bloodstream.
“So far, 27 cord blood banks have been launched across the country. Around 75,000 samples have been stored in private banks and 5,000 in public banks,” Zarrabi said.
Approximately four in every 1,000 children in Iran have CP while in the developed countries the rate is 2 to 2.5 per 1000 live births.
Cerebral palsy is a group of permanent movement disorders that appear in early childhood. Signs and symptoms vary among people. Symptoms usually include poor coordination, stiff muscles, weak muscles and tremors. There may be problem with sensation, hearing and vision, swallowing, and speaking. Babies with CP don’t roll over, sit or walk as early as other children of their age. Difficulty with ability to think or reason and seizures occur in about one-third of people with CP.
CP is caused by abnormal development or damage to the parts of the brain that control movement, balance, and posture. Most often the problems occur during pregnancy; however they may also occur during childbirth or shortly after birth. While the cause is unknown, risk factors such as preterm birth, being a twin, certain infections during pregnancy such as rubella, exposure to methyl-mercury during pregnancy, difficult delivery, head trauma during the first years of life, and inherited genetic disorders, are some of the causes.